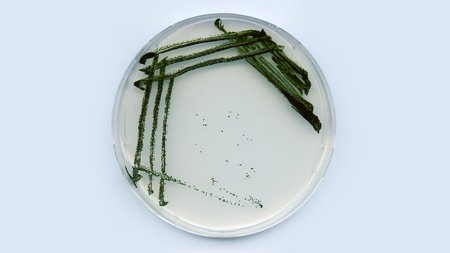

Bioökonomie ist vielfältig und eröffnet stetig neue Wege, unsere Wirtschaft und Produktion nachhaltig zu gestalten. Expertinnen und Experten aus Wissenschaft, Gesellschaft und Politik beschäftigen sich täglich mit neuen Möglichkeiten, ihre Entwicklung voranzutreiben. Hier geben wir Ihnen Einblicke in spannende Projekte, aktuelle Forschungsthemen und gesellschaftliche Herausforderungen.